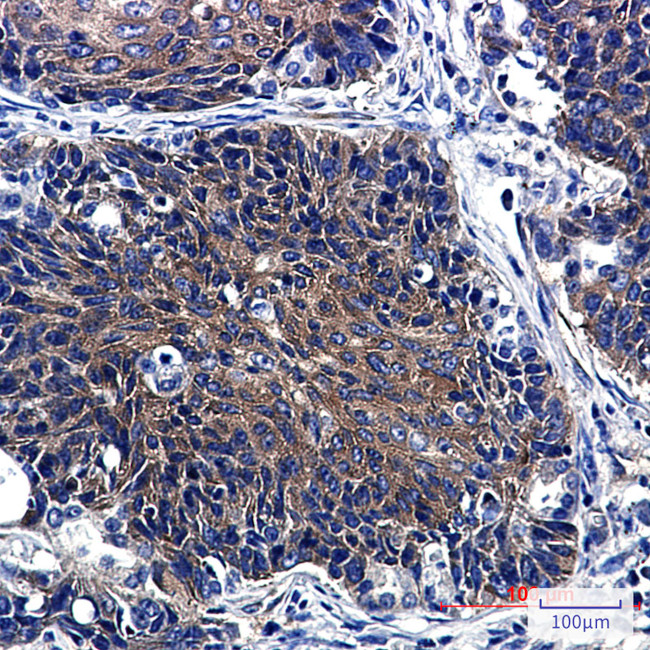
P4HTM Antibody in Immunohistochemistry (Paraffin) (IHC (P))

Search
Invitrogen
P4HTM Recombinant Rabbit Monoclonal Antibody (K01_2M66)
{{$productOrderCtrl.translations['antibody.pdp.commerceCard.promotion.promotions']}}
{{$productOrderCtrl.translations['antibody.pdp.commerceCard.promotion.viewpromo']}}
{{$productOrderCtrl.translations['antibody.pdp.commerceCard.promotion.promocode']}}: {{promo.promoCode}} {{promo.promoTitle}} {{promo.promoDescription}}. {{$productOrderCtrl.translations['antibody.pdp.commerceCard.promotion.learnmore']}}
图: 1 / 2
P4HTM Antibody (MA564081) in IHC (P)


产品信息
MA564081
种属反应
宿主/亚型
Expression System
分类
类型
克隆号
抗原
偶联物
形式
浓度
规格
纯化类型
保存液
内含物
保存条件
运输条件
RRID
靶标信息
Prolyl hydroxylase 4 is a prolyl hydroxylase that modifies HIF-alpha. Classic prolyl hydroxylases are found in the endoplasmic reticulum and modify collagen, whereas HIF is an intracellular protein and the prolyl hydroxylase sites do not resemble those modifying collagen. HIF is a transcriptional complex that plays a critical role in oxygen homeostasis. Prolyl hydroxylase is an essential component of the pathway through which cells sense oxygen. In the presence of oxygen, prolyl hydroxylases convert specific prolyl residues in HIF-alpha to hydroxyproline, leading to HIF-alpha destruction. Low oxygen levels, sensed at the cellular level, cause the HIF conversion to be reduced so that HIF is stable and there is increased angiogenesis. Prolyl hydroxylase 4, specifically, catalyzes the posttranslational formation of 4-hydroxyproline in HIF alpha proteins. It may function as a cellular oxygen sensor and, under normoxic conditions, may targets HIF through the hydroxylation for proteasomal degradation via the von Hippel-Lindau ubiquitylation complex.
仅用于科研。不用于诊断过程。未经明确授权不得转售。
篇参考文献 (0)
生物信息学
蛋白别名: FLJ20262; HIF-PH4; HIF-prolyl hydroxylase 4; HPH-4; hypoxia-inducible factor prolyl 4-hydroxylase; Hypoxia-inducible factor prolyl hydroxylase 4; P4H TM; P4H with transmembrane domain; P4H-TM; PH 4; proline 4-hydroxylase; prolyl 4-hydroxylase, transmembrane (endoplasmic reticulum); Prolyl hydroxlase domain-containing 4; Transmembrane prolyl 4-hydroxylase; unnamed protein product
基因别名: EGLN4; HIDEA; HIFPH4; P4H-TM; P4HTM; PH-4; PH4; PHD4
UniProt ID: (Human) Q9NXG6
Entrez Gene ID: (Human) 54681